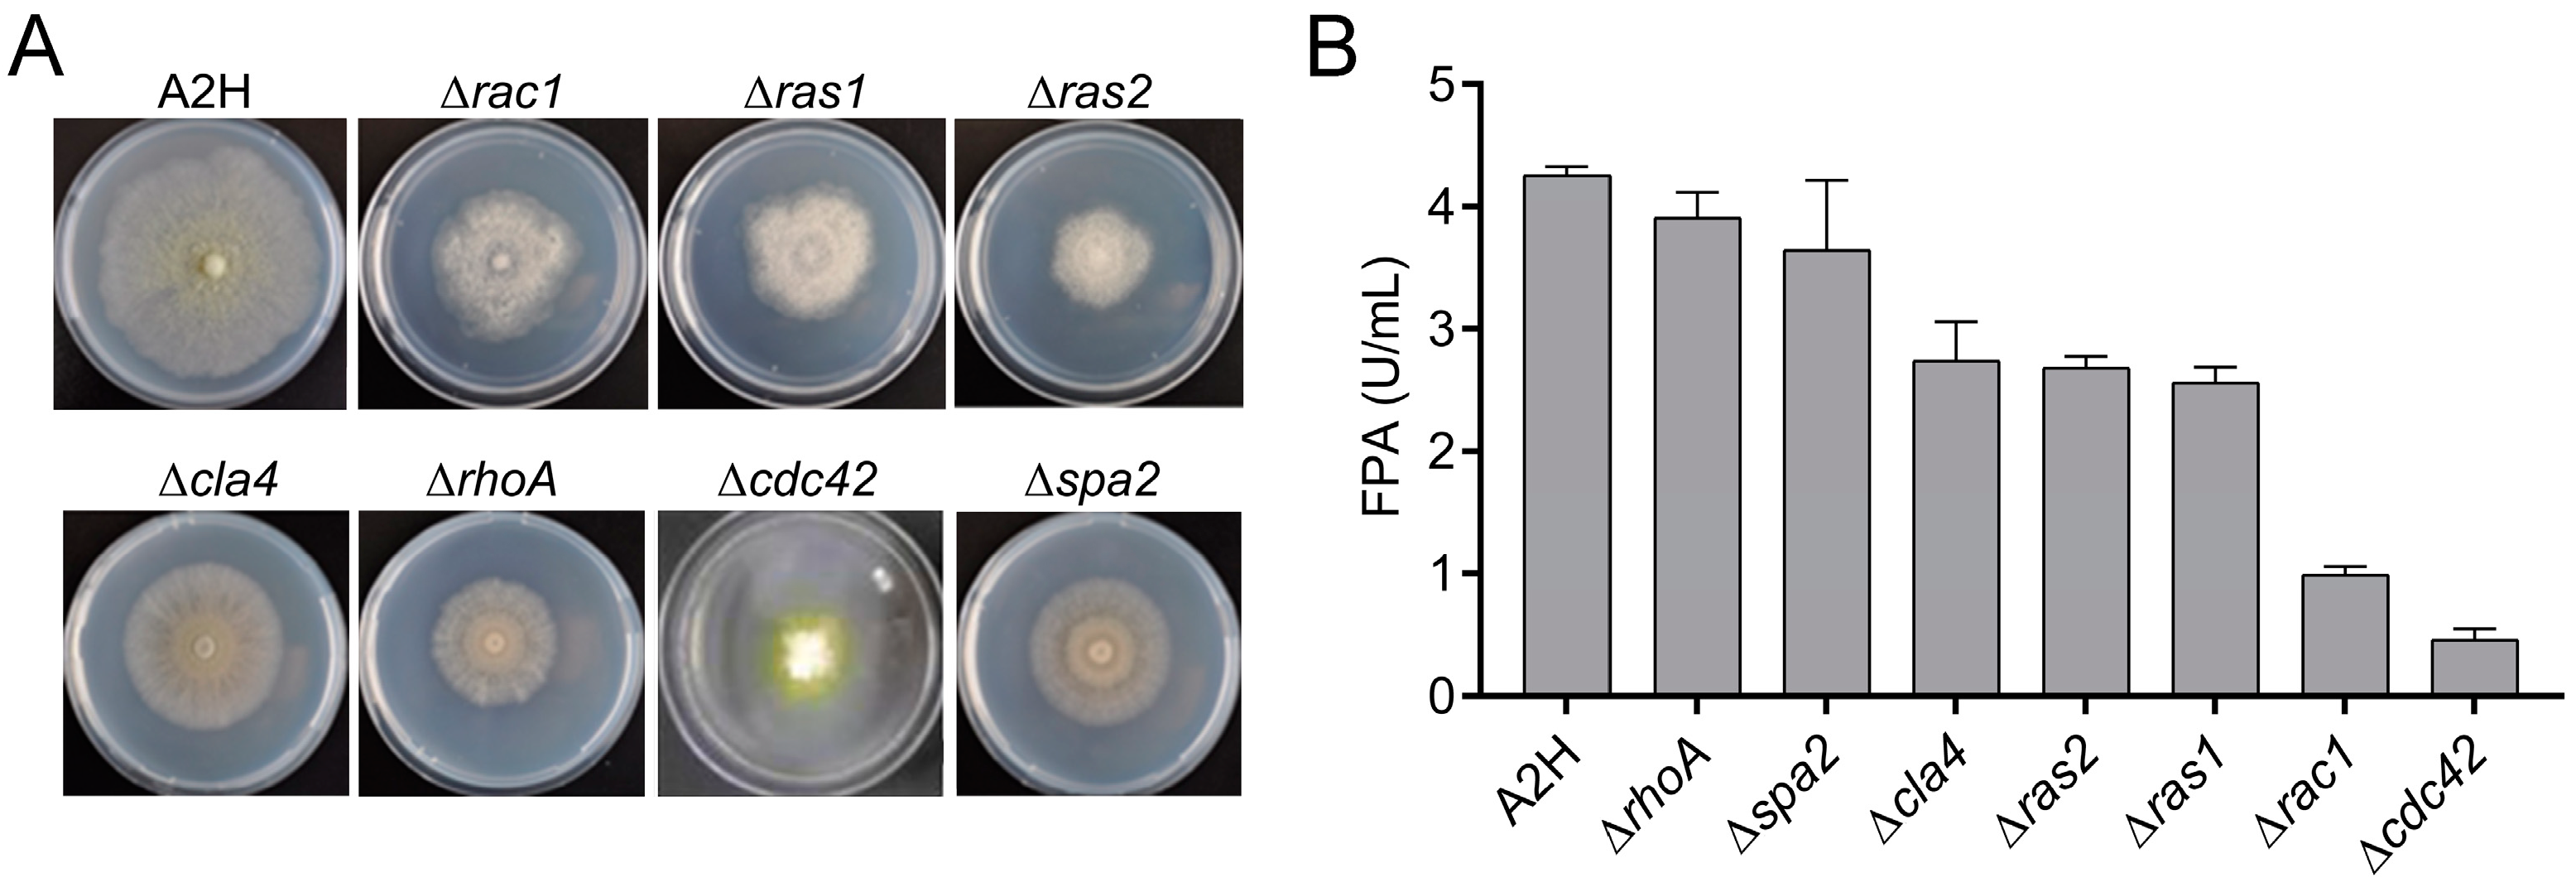
Fermentation 10 00026 g001

Improved Cellulase Production of Trichoderma reesei by Regulating Mycelium Morphology
Abstract
1. Introduction
2. Materials and Methods
2.1. Fungal Strains, Media, and Cultivation Conditions
2.2. Plasmid Construction
2.3. PEG-Mediated Transformation of T. reesei
2.4. Screening of Transformants by Flow Cytometry Analysis
2.5. Growth Test
2.6. Protein and Enzyme Assays
2.7. RNA Isolation and Quantitative Real-Time PCR
3. Results and Discussion
3.1. Deletion of cdc42 Leads to Growth Defect and Impaired Cellulase Production
3.2. Cdc42 Function in Polarized Apical Growth and Branching
3.3. Enhanced Protein Secretion and Cellulase Genes Expression in OCdc42 Strain
3.4. Exoproteome Analysis of Secreted Proteins
3.5. Mechanism of Regulation of Morphogenesis of T. reesei via Rho GTPases
4. Conclusions
Supplementary Materials
Author Contributions
Funding
Institutional Review Board Statement
Informed Consent Statement
Data Availability Statement
Conflicts of Interest
References
- Peterson, R.; Nevalainen, H. Trichoderma reesei RUT-C30—Thirty years of strain improvement. Microbiology 2012, 158, 58–68. [Google Scholar] [CrossRef] [PubMed]
- Higuchi, Y. Membrane traffic in Aspergillus oryzae and related filamentous fungi. J. Fungi 2021, 7, 534. [Google Scholar] [CrossRef]
- Takeshita, N. Coordinated process of polarized growth in filamentous fungi. Biosci. Biotechnol. Biochem. 2016, 80, 1693–1699. [Google Scholar] [CrossRef] [PubMed]
- Fiedler, M.R.M.; Barthel, L.; Kubisch, C.; Nai, C.; Meyer, V. Construction of an improved Aspergillus niger platform for enhanced glucoamylase secretion. Microb. Cell Factories 2018, 17, 95. [Google Scholar] [CrossRef] [PubMed]
- te Biesebeke, R.; Record, E.; van Biezen, N.; Heerikhuisen, M.; Franken, A.; Punt, P.J.; van den Hondel, C.A.M.J.J. Branching mutants of Aspergillus oryzae with improved amylase and protease production on solid substrates. Appl. Microbiol. Biotechnol. 2005, 69, 44–50. [Google Scholar] [CrossRef]
- Lin, L.; Sun, Z.; Li, J.; Chen, Y.; Liu, Q.; Sun, W.; Tian, C. Disruption of gul-1 decreased the culture viscosity and improved protein secretion in the filamentous fungus Neurospora crassa. Microb. Cell Factories 2018, 17, 96. [Google Scholar] [CrossRef] [PubMed]
- Bocking, S.P.; Wiebe, M.G.; Robson, G.D.; Hansen, K.; Christiansen, L.H.; Trinci, A.P. Effect of branch frequency in Aspergillus oryzae on protein secretion and culture viscosity. Biotechnol. Bioeng. 1999, 65, 638–648. [Google Scholar] [CrossRef]
- Murali, A.; Rajalingam, K. Small Rho GTPases in the control of cell shape and mobility. Cell. Mol. Life Sci. 2014, 71, 1703–1721. [Google Scholar] [CrossRef]
- Kwon, M.J.; Arentshorst, M.; Roos, E.D.; van den Hondel, C.A.; Meyer, V.; Ram, A.F. Functional characterization of Rho GTPases in Aspergillus niger uncovers conserved and diverged roles of Rho proteins within filamentous fungi. Mol. Microbiol. 2011, 79, 1151–1167. [Google Scholar] [CrossRef]
- Wendland, J.; Philippsen, P. Cell polarity and hyphal morphogenesis are controlled by multiple Rho-protein modules in the filamentous ascomycete Ashbya gossypii. Genetics 2001, 157, 601–610. [Google Scholar] [CrossRef]
- Guest, G.M.; Lin, X.; Momany, M. Aspergillus nidulans RhoA is involved in polar growth, branching, and cell wall synthesis. Fungal Genet. Biol. 2004, 41, 13–22. [Google Scholar] [CrossRef] [PubMed]
- Pham, C.D.; Yu, Z.; Sandrock, B.; Bölker, M.; Gold, S.E.; Perlin, M.H. Ustilago maydis Rho1 and 14-3-3 homologues participate in pathways controlling cell separation and cell polarity. Eukaryot. Cells 2009, 8, 977–989. [Google Scholar] [CrossRef] [PubMed]
- Richthammer, C.; Enseleit, M.; Sanchez-Leon, E.; März, S.; Heilig, Y.; Riquelme, M.; Seiler, S. RHO1 and RHO2 share partially overlapping functions in the regulation of cell wall integrity and hyphal polarity in Neurospora crassa. Mol. Microbiol. 2012, 85, 716–733. [Google Scholar] [CrossRef] [PubMed]
- Zhang, C.; Wang, Y.; Wang, J.; Zhai, Z.; Zhang, L.; Zheng, W.; Zheng, W.; Yu, W.; Zhou, J.; Lu, G.; et al. Functional characterization of Rho family small GTPases in Fusarium graminearum. Fungal Genet. Biol. 2013, 61, 90–99. [Google Scholar] [CrossRef] [PubMed]
- Xu, X.; Wang, Y.; Tian, C.; Liang, Y. The Colletotrichum gloeosporioides RhoB regulates cAMP and stress response pathways and is required for pathogenesis. Fungal Genet. Biol. 2016, 96, 12–24. [Google Scholar] [CrossRef] [PubMed]
- Nordmann, D.; Lickfeld, M.; Warnsmann, V.; Wiechert, J.; Jendretzki, A.; Schmitz, H.P. The small GTP-binding proteins AgRho2 and AgRho5 regulate tip-branching, maintenance of the growth axis and actin-ring-integrity in the filamentous fungus Ashbya gossypii. PLoS ONE 2014, 9, e106236. [Google Scholar] [CrossRef] [PubMed]
- Fu, T.; Kim, J.O.; Han, J.H.; Gumilang, A.; Lee, Y.H.; Kim, K.S. A small GTPase RHO2 plays an important role in pre-infection development in the rice blast pathogen Magnaporthe oryzae. Plant Pathol. J. 2018, 34, 470–479. [Google Scholar] [CrossRef]
- Yang, L.; Li, X.; Bai, N.; Yang, X.; Zhang, K.Q.; Yang, J. Transcriptomic analysis reveals that Rho GTPases regulate trap development and lifestyle transition of the nematode-trapping fungus Arthrobotrys oligospora. Microbiol. Spectr. 2022, 10, e0175921. [Google Scholar] [CrossRef]
- An, B.; Li, B.; Qin, G.; Tian, S. Function of small GTPase Rho3 in regulating growth, conidiation and virulence of Botrytis cinerea. Fungal Genet. Biol. 2015, 75, 46–55. [Google Scholar] [CrossRef]
- Vasara, T.; Salusjärvi, L.; Raudaskoski, M.; Keränen, S.; Penttilä, M.; Saloheimo, M. Interactions of the Trichoderma reesei rho3 with the secretory pathway in yeast and, T. reesei. Mol. Microbiol. 2001, 42, 1349–1361. [Google Scholar] [CrossRef]
- Li, Q.; Chen, X.; Lin, L.; Zhang, L.; Wang, L.; Bao, J.; Zhang, D. Transcriptomic dynamics of active and inactive states of Rho GTPase MoRho3 in Magnaporthe oryzae. J. Fungi 2022, 8, 1060. [Google Scholar] [CrossRef] [PubMed]
- Si, H.; Justa-Schuch, D.; Seiler, S.; Harris, S.D. Regulation of septum formation by the Bud3-Rho4 GTPase module in Aspergillus nidulans. Genetics 2010, 185, 165–176. [Google Scholar] [CrossRef] [PubMed]
- Rasmussen, C.G.; Glass, N.L. A Rho-type GTPase, rho-4, is required for septation in Neurospora crassa. Eukaryot. Cells 2005, 4, 1913–1925. [Google Scholar] [CrossRef] [PubMed]
- Rasmussen, C.G.; Morgenstein, R.M.; Peck, S.; Glass, N.L. Lack of the GTPase RHO-4 in Neurospora crassa causes a reduction in numbers and aberrant stabilization of microtubules at hyphal tips. Fungal Genet. Biol. 2008, 45, 1027–1039. [Google Scholar] [CrossRef] [PubMed]
- Oliveira-Garcia, E.; Aliyeva-Schnorr, L.; De Oliveira Silva, A.; El Din Ghanem, S.; Thor, K.; Peiter, E.; Deising, H.B. The small Ras superfamily GTPase Rho4 of the maize anthracnose fungus Colletotrichum graminicola is required for β-1,3-glucan synthesis, cell wall integrity, and full virulence. J. Fungi 2022, 8, 997. [Google Scholar] [CrossRef]
- Araujo-Palomares, C.L.; Richthammer, C.; Seiler, S.; Castro-Longoria, E. Functional characterization and cellular dynamics of the CDC-42-RAC-CDC-24 module in Neurospora crassa. PLoS ONE 2011, 6, e27148. [Google Scholar] [CrossRef]
- Mahlert, M.; Leveleki, L.; Hlubek, A.; Sandrock, B.; Bölker, M. Rac1 and Cdc42 regulate hyphal growth and cytokinesis in the dimorphic fungus Ustilago maydis. Mol. Microbiol. 2006, 59, 567–578. [Google Scholar] [CrossRef]
- Rolke, Y.; Tudzynski, P. The small GTPase Rac and the p21-activated kinase Cla4 in Claviceps purpurea: Interaction and impact on polarity, development and pathogenicity. Mol. Microbiol. 2008, 68, 405–423. [Google Scholar] [CrossRef]
- Fitz, E.; Gamauf, C.; Seiboth, B.; Wanka, F. Deletion of the small GTPase rac1 in Trichoderma reesei provokes hyperbranching and impacts growth and cellulase production. Fungal Biol. Biotechnol. 2019, 6, 16. [Google Scholar] [CrossRef]
- Lee, N.H.; Fu, T.; Shin, J.H.; Song, Y.W.; Jang, D.C.; Kim, K.S. The small GTPase CsRAC1 is important for fungal development and pepper anthracnose in Colletotrichum scovillei. Plant Pathol. J. 2021, 37, 607–618. [Google Scholar] [CrossRef]
- Li, H.; Barker, B.M.; Grahl, N.; Puttikamonkul, S.; Bell, J.D.; Craven, K.D.; Cramer, R.A. The small GTPase RacA mediates intracellular reactive oxygen species production, polarized growth, and virulence in the human fungal pathogen Aspergillus fumigatus. Eukaryot. Cells 2011, 10, 174–186. [Google Scholar] [CrossRef] [PubMed]
- Chi, M.H.; Craven, K.D. RacA-mediated ROS signaling is required for polarized cell differentiation in conidiogenesis of Aspergillus fumigatus. PLoS ONE 2016, 11, e0149548. [Google Scholar] [CrossRef][Green Version]
- Chen, J.; Zheng, W.; Zheng, S.; Zhang, D.; Sang, W.; Chen, X.; Li, G.; Lu, G.; Wang, Z. Rac1 is required for pathogenicity and Chm1-dependent conidiogenesis in rice fungal pathogen Magnaporthe grisea. PLoS Pathog. 2008, 4, e1000202. [Google Scholar] [CrossRef] [PubMed]
- Jiang, S.S.; Yin, Y.P.; Song, Z.Y.; Zhou, G.L.; Wang, Z.K. RacA and Cdc42 regulate polarized growth and microsclerotium formation in the dimorphic fungus Nomuraea rileyi. Res. Microbiol. 2014, 165, 233–242. [Google Scholar] [CrossRef] [PubMed]
- Tanaka, A.; Takemoto, D.; Hyon, G.S.; Park, P.; Scott, B. NoxA activation by the small GTPase RacA is required to maintain a mutualistic symbiotic association between Epichloë festucae and perennial ryegrass. Mol. Microbiol. 2008, 68, 1165–1178. [Google Scholar] [CrossRef] [PubMed]
- Kayano, Y.; Tanaka, A.; Takemoto, D. Two closely related Rho GTPases, Cdc42 and RacA, of the en-dophytic fungus Epichloë festucae have contrasting roles for ROS production and symbiotic infection synchronized with the host plant. PLoS Pathog. 2018, 14, e1006840. [Google Scholar] [CrossRef]
- Kwon, M.J.; Nitsche, B.M.; Arentshorst, M.; Jørgensen, T.R.; Ram, A.F.; Meyer, V. The transcriptomic signature of RacA activation and inactivation provides new insights into the morphogenetic network of Aspergillus niger. PLoS ONE 2013, 8, e68946. [Google Scholar] [CrossRef]
- Qin, L.; Yang, L.; Zhao, J.; Zeng, W.; Su, M.; Wang, S.; Yuan, J. GTPase Rac regulates conidiation, AFB1 production and stress response in pathogenic fungus Aspergillus flavus. Toxins 2022, 14, 581. [Google Scholar] [CrossRef]
- Virag, A.; Lee, M.P.; Si, H.; Harris, S.D. Regulation of hyphal morphogenesis by cdc42 and rac1 homologues in Aspergillus nidulans. Mol. Microbiol. 2007, 66, 1579–1596. [Google Scholar] [CrossRef]
- Si, H.; Rittenour, W.R.; Harris, S.D. Roles of Aspergillus nidulans Cdc42/Rho GTPase regulators in hyphal morphogenesis and development. Mycologia 2016, 108, 543–555. [Google Scholar] [CrossRef]
- Boyce, K.J.; Hynes, M.J.; Andrianopoulos, A. The CDC42 homolog of the dimorphic fungus Penicillium marneffei is required for correct cell polarization during growth but not development. J. Bacteriol. 2001, 183, 3447–3457. [Google Scholar] [CrossRef] [PubMed]
- Weber, M.; Salo, V.; Uuskallio, M.; Raudaskoski, M. Ectopic expression of a constitutively active Cdc42 small GTPase alters the morphology of haploid and dikaryotic hyphae in the filamentous homobasidiomycete Schizophyllum commune. Fungal Genet. Biol. 2005, 42, 624–637. [Google Scholar] [CrossRef] [PubMed]
- Chen, C.; Ha, Y.S.; Min, J.Y.; Memmott, S.D.; Dickman, M.B. Cdc42 is required for proper growth and development in the fungal pathogen Colletotrichum trifolii. Eukaryot. Cells 2006, 5, 155–166. [Google Scholar] [CrossRef] [PubMed][Green Version]
- Scheffer, J.; Chen, C.; Heidrich, P.; Dickman, M.B.; Tudzynski, P. A CDC42 homologue in Claviceps purpurea is involved in vegetative differentiation and is essential for pathogenicity. Eukaryot. Cells 2005, 4, 1228–1238. [Google Scholar] [CrossRef] [PubMed][Green Version]
- Wang, X.; Xu, X.; Liang, Y.; Wang, Y.; Tian, C. A Cdc42 homolog in Colletotrichum gloeosporioides regulates morphological development and is required for ROS-mediated plant infection. Curr. Genet. 2018, 64, 1153–1169. [Google Scholar] [CrossRef] [PubMed]
- Lichius, A.; Goryachev, A.B.; Fricker, M.D.; Obara, B.; Castro-Longoria, E.; Read, N.D. CDC-42 and RAC-1 regulate opposite chemotropisms in Neurospora crassa. J. Cell. Sci. 2014, 127, 1953–1965. [Google Scholar] [CrossRef]
- Kokkelink, L.; Minz, A.; Al-Masri, M.; Giesbert, S.; Barakat, R.; Sharon, A.; Tudzynski, P. The small GTPase BcCdc42 affects nuclear division, germination and virulence of the gray mold fungus Botrytis cinerea. Fungal Genet. Biol. 2011, 48, 1012–1019. [Google Scholar] [CrossRef]
- Guan, Y.; Wang, D.; Lin, X.; Li, X.; Lv, C.; Wang, D.; Zhang, L. Unveiling a novel role of Cdc42 in pyruvate metabolism pathway to mediate insecticidal activity of Beauveria bassiana. J. Fungi 2022, 8, 394. [Google Scholar] [CrossRef]
- He, R.; Ding, R.; Heyman, J.A.; Zhang, D.; Tu, R. Ultra-high-throughput picoliter-droplet microfluidics screening of the industrial cellulase-producing filamentous fungus Trichoderma reesei. J. Ind. Microbiol. Biotechnol. 2019, 46, 1603–1610. [Google Scholar] [CrossRef]
- Li, F.; Liu, Q.; Li, X.; Zhang, C.; Li, J.; Sun, W.; Liu, D.; Xiao, D.; Tian, C. Construction of a new thermophilic fungus Myceliophthora thermophila platform for enzyme production using a versatile 2A peptide strategy combined with efficient CRISPR-Cas9 system. Biotechnol. Lett. 2020, 42, 1181–1191. [Google Scholar] [CrossRef]
- Li, J.; Wang, X.; Zou, J.; Yang, K.; Wang, X.; Wang, Y.; Zhang, H.; Huang, H.; Su, X.; Yao, B.; et al. Identification and characterization of the determinants of copper resistance in the acidophilic fungus Acidomyces richmondensis MEY-1 using the CRISPR/Cas9 system. Appl. Environ. Microbiol. 2023, 89, e0210722. [Google Scholar] [CrossRef] [PubMed]
- Xu, X.; Li, J.; Shi, P.; Ji, W.; Liu, B.; Zhang, Y.; Yao, B.; Fan, Y.; Zhang, W. The use of T-DNA insertional mutagenesis to improve cellulase production by the thermophilic fungus Humicola insolens Y1. Sci. Rep. 2016, 6, 31108. [Google Scholar] [CrossRef] [PubMed]
- Li, J.; Xu, X.; Shi, P.; Liu, B.; Zhang, Y.; Zhang, W. Overexpression and characterization of a novel endo-β-1,3(4)-glucanase from thermophilic fungus Humicola insolens Y1. Protein Expr. Purif. 2017, 138, 63–68. [Google Scholar] [CrossRef] [PubMed]
- He, R.; Li, C.; Ma, L.; Zhang, D.; Chen, S. Effect of highly branched hyphal morphology on the enhanced production of cellulase in Trichoderma reesei DES-15. 3 Biotech 2016, 6, 214. [Google Scholar] [CrossRef] [PubMed]
- Livak, K.J.; Schmittgen, T.D. Analysis of relative gene expression data using real-time quantitative PCR and the 2−ΔΔCT Method. Methods 2001, 25, 402–408. [Google Scholar] [CrossRef] [PubMed]
- Momany, M. Polarity in filamentous fungi: Establishment, maintenance and new axes. Curr. Opin. Microbiol. 2002, 5, 580–585. [Google Scholar] [CrossRef] [PubMed]
- Subramanian, V.; Schuster, L.A.; Moore, K.T.; Taylor, L.E.; Baker, J.O.; Vander Wall, T.A.; Linger, J.G.; Himmel, M.E.; Decker, S.R. A versatile 2A peptide-based bicistronic protein expressing platform for the industrial cellulase producing fungus, Trichoderma reesei. Biotechnol. Biofuels 2017, 10, 34. [Google Scholar] [CrossRef] [PubMed]
- Bischof, R.H.; Ramoni, J.; Seiboth, B. Cellulases and beyond: The first 70 years of the enzyme producer Trichoderma reesei. Microb. Cell Factories 2016, 15, 106. [Google Scholar] [CrossRef]
- Sun, X.; Liang, Y.; Wang, Y.; Zhang, H.; Zhao, T.; Yao, B.; Luo, H.; Huang, H.; Su, X. Simultaneous manipulation of multiple genes within a same regulatory stage for iterative evolution of Trichoderma reesei. Biotechnol. Biofuels Bioprod. 2022, 15, 26. [Google Scholar] [CrossRef]
- Portnoy, T.; Margeot, A.; Seidl-Seiboth, V.; Le Crom, S.; Ben Chaabane, F.; Linke, R.; Seiboth, B.; Kubicek, C.P. Differential regulation of the cellulase transcription factors XYR1, ACE2, and ACE1 in Trichoderma reesei strains producing high and low levels of cellulase. Eukaryot. Cells 2011, 10, 262–271. [Google Scholar] [CrossRef]
- Gordon, C.L.; Archer, D.B.; Jeenes, D.J.; Doonan, J.H.; Wells, B.; Trinci, A.P.; Robson, G.D. A glucoamylase::GFP gene fusion to study protein secretion by individual hyphae of Aspergillus niger. J. Microbiol. Methods 2000, 42, 39–48. [Google Scholar] [CrossRef] [PubMed]
- Peberdy, J.F. Protein secretion in filamentous fungi-trying to understand a highly productive black box. Trends Biotechnol. 1994, 12, 50–57. [Google Scholar] [CrossRef] [PubMed]
- Zhang, J.; Zhang, Y.; Zhong, Y.; Qu, Y.; Wang, T. Ras GTPases modulate morphogenesis, sporulation and cellulase gene expression in the cellulolytic fungus Trichoderma reesei. PLoS ONE 2012, 7, e48786. [Google Scholar] [CrossRef] [PubMed]
- Mösch, H.U.; Kübler, E.; Krappmann, S.; Fink, G.R.; Braus, G.H. Crosstalk between the Ras2p-controlled mitogen-activated protein kinase and cAMP pathways during invasive growth of Saccharomyces cerevisiae. Mol. Biol. Cell. 1999, 10, 1325–1335. [Google Scholar] [CrossRef]
- Lowy, D.R.; Willumsen, B.M. Function and regulation of ras. Annu. Rev. Biochem. 1993, 62, 851–891. [Google Scholar] [CrossRef]
- Pérez, P.; Soto, T.; Gómez-Gil, E.; Cansado, J. Functional interaction between Cdc42 and the stress MAPK signaling pathway during the regulation of fission yeast polarized growth. Int. Microbiol. 2020, 23, 31–41. [Google Scholar] [CrossRef]

Disclaimer/Publisher’s Note: The statements, opinions and data contained in all publications are solely those of the individual author(s) and contributor(s) and not of MDPI and/or the editor(s). MDPI and/or the editor(s) disclaim responsibility for any injury to people or property resulting from any ideas, methods, instructions or products referred to in the content. |
© 2023 by the authors. Licensee MDPI, Basel, Switzerland. This article is an open access article distributed under the terms and conditions of the Creative Commons Attribution (CC BY) license (https://creativecommons.org/licenses/by/4.0/).
Share and Cite
Jiang, F.; Tian, J.; Yuan, J.; Wang, S.; Bao, T.; Chen, Q.; Gao, L.; Li, J.; Ma, L. Improved Cellulase Production of Trichoderma reesei by Regulating Mycelium Morphology. Fermentation 2024, 10, 26. https://doi.org/10.3390/fermentation10010026
Jiang F, Tian J, Yuan J, Wang S, Bao T, Chen Q, Gao L, Li J, Ma L. Improved Cellulase Production of Trichoderma reesei by Regulating Mycelium Morphology. Fermentation. 2024; 10(1):26. https://doi.org/10.3390/fermentation10010026
Chicago/Turabian StyleJiang, Fangting, Jiudong Tian, Jie Yuan, Shengjie Wang, Tongtong Bao, Qiuhui Chen, Le Gao, Jinyang Li, and Lijuan Ma. 2024. "Improved Cellulase Production of Trichoderma reesei by Regulating Mycelium Morphology" Fermentation 10, no. 1: 26. https://doi.org/10.3390/fermentation10010026
APA StyleJiang, F., Tian, J., Yuan, J., Wang, S., Bao, T., Chen, Q., Gao, L., Li, J., & Ma, L. (2024). Improved Cellulase Production of Trichoderma reesei by Regulating Mycelium Morphology. Fermentation, 10(1), 26. https://doi.org/10.3390/fermentation10010026

